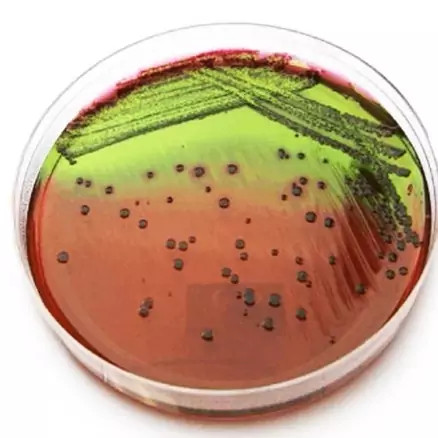
null

کالاهای موجود

پیپت پرکن دستی 10 میلی لیتر(پیپت فیلر پوار اتوماتیک)
350,000 

کیت بزرگنمایی صفحه نمایش موبایل (ارسال رایگان)
227,000 

پیست آزمایشگاهی(آب فشان) یک لیتری
150,000 

پیپت پرکن برقی دراگون DLAB مدل LEVO PLUS
11,050,000 

پیست آزمایشگاهی (آب فشان) 500 میلی لیتر
100,000 

کیت اندازه گیری گاز کربنیک واهب روش تیتراسیون
487,500 

کیت بزرگنمایی صفحه نمایش موبایل
177,000 

کیت کلر سنج واهب v314
487,500 

رک فالکون سایز 15و 50 قابل اتوکلاو
150,000 

لوله فالکون 15 سی سی بسته 50 عددی غیر استریل
400,000 

پیپت مدرج 0.5 سی سی شیشه ای مدرج
85,000 

کیت اندازه گیری قلیائیت واهب V_702 روش تیتراسیون
357,500 

یورین باتل استریل کارتن 500 عددی آزمایشگاهی
1,350,000 

کیت سختی سنج کل واهب VM212 روش تیتراسیون مناسب آب خام و تصفیه
414,400 

کیت سختی سنج کل واهب VM_210 روش تیتراسیون مناسب آب خام
406,200 

محیط کشت PDA کیولب 100 گرمی
750,000 

کیت اندازه گیری فسفات واهب آزمایشگاهی
1,381,200 

پیپت پرکن شارژی سارتریوس آلمان تفنگی پیپتور برقی
40,000,000 

پیپت پرکن DLAB مدل LEVO ME آزمایشگاهی
8,000,000 

رک فالکون 50 سی سی 50 خانه تعداد کارتن 50 عددی
4,700,000 

آب مقطر سه بار تقطیر 5 لیتری پلمپ
99,000 

کاغذ پی اچ مرک آلمان اصل
1,500,000 

پوآر پیپت dn دو زمانه آزمایشگاهی
650,000 

پیپت پرکن دستی 25 میلی لیتر(پیپت فیلر پوار اتوماتیک)
350,000 

کیت اندازه گیری نیترات واهب V_501 رنگ سنجی
487,500 

کیت اندازه گیری منگنز واهب آزمایشگاهی
1,218,800 

پیپت مدرج 1 سی سی شیشه ای مقاوم در اسید
95,000 

کیت تست کلر D P D Chlorine test kit (D.P.D) برند A k
480,000 

پیپت پاستور 3 میل کارتن 500 عددی جنس پلاستیکی
375,000 

محیط کشت برلیانت گرین براث کیولب 100 گرمی
1,200,000 

پیپت فیلر برند BRAND برقی دیجیتال
55,000,000 

کیت اندازه گیری ph پی اچ واهب v_512
325,000 

کیت اندازه گیری سولفیت واهب v_805 روش تیتراسیون
406,200 

کیت اندازه گیری کلرید واهب روش تیتراسیون
455,000 

کاغذ پی اچ دفترچه ای تورنسل چینی رنج 1 تا 14
100,000 

کیت تشخیص متانول از اتانول با بسته بندی جدید و گارانتی
500,000 

کاغذ پی اچ 100ph برگ تک پد آزمایشگاهی
100,000 

کیت تست سلامت موتور و تشخیص نشتی واشر سرسیلندر سی اس CS کارشناسی خودرو
550,000 

کاغذ پی اچ رولی ph متر رنج 1 تا 10 مدل نواری
350,000 

کیت تست الکل تقلبی متانول اتانول 5 تستی خانگی شرکت KPG کارمانیا پارس ژن
850,000 

کیت اندازه گیری ید در نمک واهب روش رنگ سنجی
243,800 

کیت دقیق آزمایش محلول تست نیکل سنگ
2,000,000 

رک نوک سمپلر آبی و زرد قابل اتوکلاو 96 خانه
90,000 

لوله فالکون 50 سی سی غیراستریل بسته 50 عددی
480,000 

سر سمپلر آبی بسته 500 عددی اپندروف آزمایشگاهی
300,000 

محیط کشت تریپتیک سوی آگار TSA کیولب 100 گرمی
750,000 

کیت اندازه گیری نیتریت واهب V_707 روش رنگ سنجی
455,000 

کیت اندازه گیری آهن واهب روش رنگ سنجی
471,200 

کیت سختی سنج کل واهب v_210 روش تیتراسیون مناسب آب خام
406,200 

کیت اندازه گیری سیلیس واهب V_706 روش رنگ سنجی
406,200 

محیط کشت KF Agar کیولب 100 گرمی
800,000
محیط کشت ائوزین متیلن بلو (EMB) کیولب 100 گرمی
750,000 

کیت اندازه گیری هیدرازین V_806 واهب روش رنگ سنجی
471,200 

محیط کشت VRB کیولب 100 گرمی
1,200,000 

محیط کشت LSB مرک 500گرمی لوریل سولفات براث
3,280,000 

محیط کشت میکروبیولوژی OSA MERCK 500گرمی
5,600,000 

کیت اندازه گیری کلسیم واهب V_701 روش تیتراسیون
406,200 

کیت متانول 10 تستی نوند سلامت تستر الکل تقلبی جدید
2,400,000 

کیتوسان high(سبز گسترش آذین ترکان) آزمایشگاهی
200,000 

محیط کشت عصاره مغز و قلب آگار(BHIA) کیولب 100 گرمی
900,000 

محیط کشت 500 گرمی مرک VRB (Violet Red Bile Lactose) agar
3,700,000 

کیت اندازه گیری آرسنیک واهب V_808 روش رنگ سنجی
975,000 

کیت اندازه گیری هیدروژن سولفید واهب VM_805
1,007,500 

کیت اندازه گیری ازن واهب v_709 به روش رنگ سنجی
406,200 

کیت اندازه گیری اسیدیته واهب روش تیتراسیون
373,800 

کیت اندازه گیری آمونیاک واهب V_807 روش رنگ سنجی
487,500 

محیط کشت 100 گرمی کیولب DRBC
1,200,000 

محیط کشت MRS واحد 100 گرمی کیولب
1,200,000 

کیت کلر و پی اچ رنج بالا ایرانی ماد آزما (استخری)
600,000 